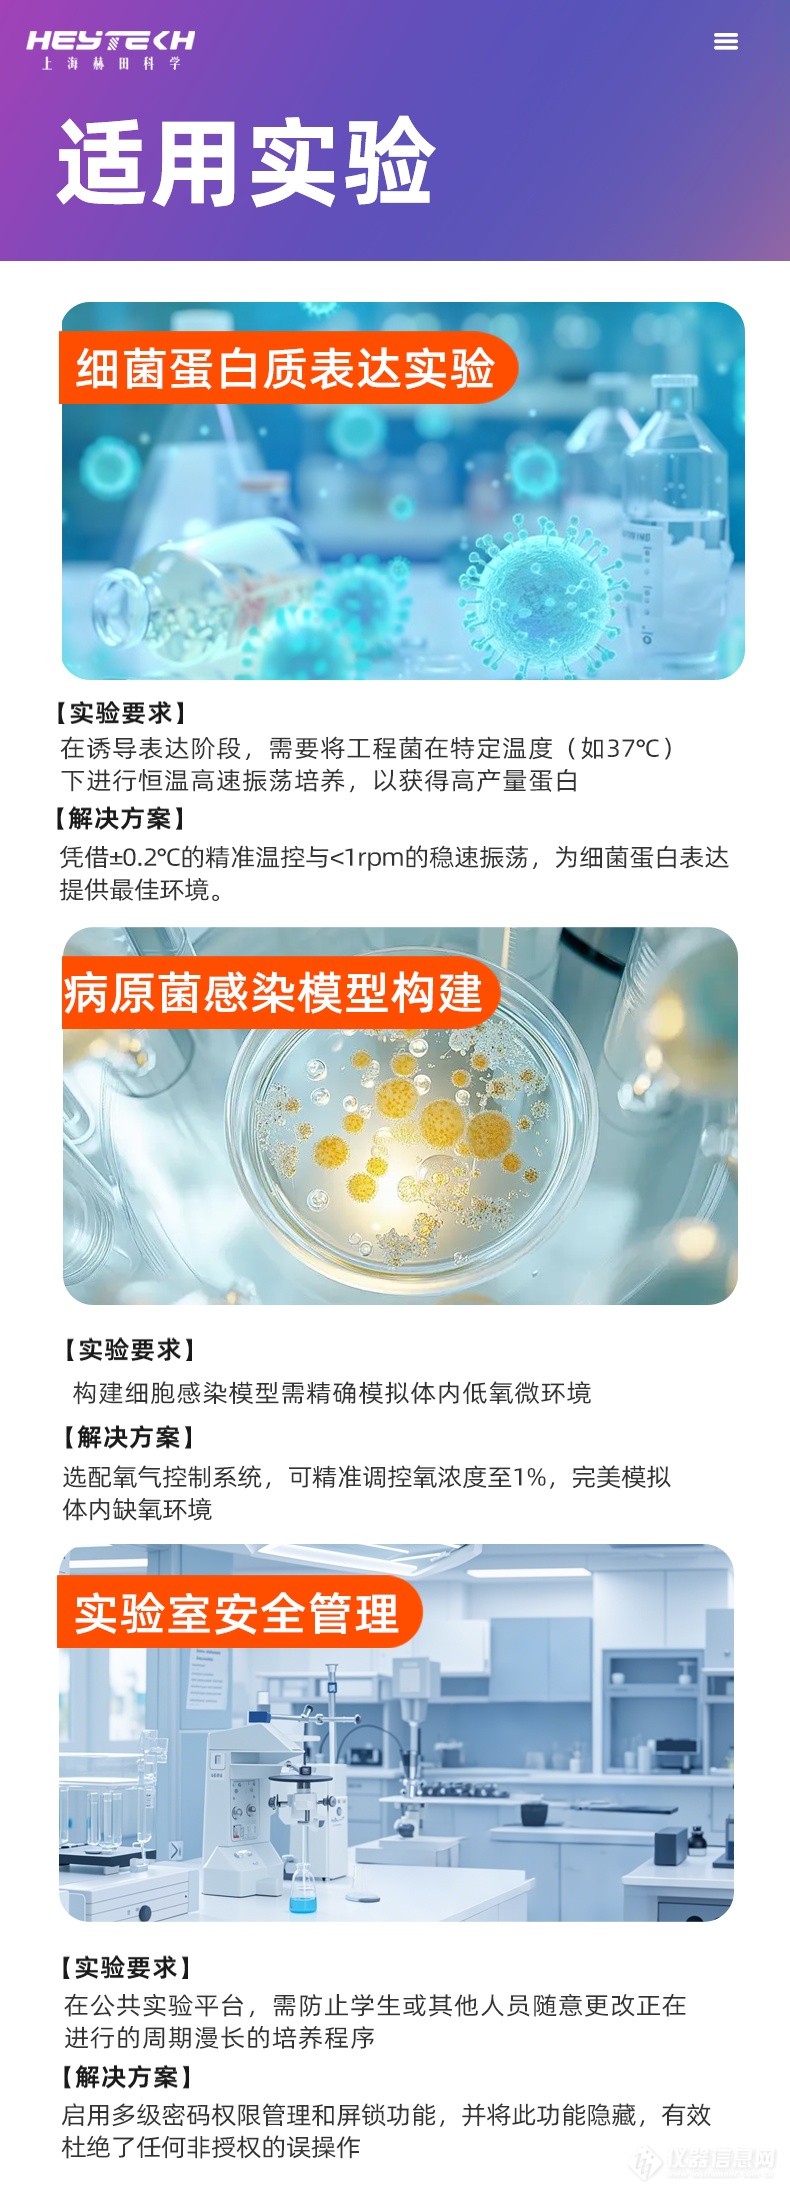

搜索
品牌:上海赫田/Herrytech
产地:上海
型号:YQ-A400
400-616-7676转2666
核心参数
仪器介绍







为了让您更清晰地了解迷你叠加摇床的规格,我们将核心参数汇总如下:
参数类别 | 具体规格 |
型号 | YQ-A400 叠加 |
控温范围 | 只加热:室温+5~60℃ |
温控精度 | 0.1℃ |
温度波动 | ≤±0.5℃ |
控制系统 | 大型彩色触摸屏,可编程、可预约、可看曲线 |
频率范围 | 30~300rpm(±1rpm) |
震荡模式 | 标配回旋,可选配往复 |
摆振幅度 | 标配Φ26mm,可选配φ35mm |
托盘尺寸 | 400×370mm |
最大容量 | 每层:250ml×12,500ml×9,1000ml×6,2000ml×4,3000ml×2 |
定时范围 | 每段0~999分钟/小时 |
照明与灭菌 | 每层配备独立照明灯与紫外杀菌灯 |
标配夹具 | 万能弹簧夹 |
电源 | 200V 50Hz |
选配项 | 高温模块(85℃);低温模块(4℃) |

精准控温与大容量振荡的理想之选,适用于多种实验室场景
在实验室日常的细胞培养、细菌振荡及样品混匀等工作中,一台性能稳定、操作便捷且性价比高的台式摇床至关重要。YQ-A400迷你叠加摇床(恒温摇床/振荡培养箱)凭借其精准的温控系统、灵活的振荡模式与宽敞的托盘设计,成为高校实验室、质检部门及科研单位的理想选择。
对于实验室主任和部门负责人而言,设备的“价值”远不止于价格标签。迷你叠加摇床的价值体现在其为核心实验提供的可靠保障与操作便捷性上。
精准的控温,为实验结果保驾护航
价值点:细胞培养、细菌发酵等实验对温度极其敏感。迷你叠加摇床提供室温+5℃至60℃ 的精确加热控温范围,0.1℃ 的高精度控制,配合 ≤±0.5℃ 的温度波动度,确保了培养环境的高度均一与稳定,从源头保障实验数据的重复性与准确性。
智能控制系统,化繁为简,高效管理
价值点: 内置大型彩色触摸屏,操作直观如智能手机。支持程序编辑、启动预约、实时曲线查看等功能。这意味着您可以提前设定好复杂的温度、转速程序,实现无人值守运行;通过曲线回顾,对实验过程一目了然,极大地提升了实验效率与管理水平。
灵活的空间与振荡模式,应对多样实验需求
价值点: 尽管被称为“迷你”,但其承载能力不容小觑。提供30-300rpm 的宽频率范围,精度达±1rpm。标配回旋模式,并可选配往复模式,满足不同菌种和细胞的培养偏好。多种可选摆振幅度,进一步增加了应用的灵活性。
超越标准的增值亮点
人性化设计: 每层独立的照明灯便于观察,紫外杀菌灯方便了使用前后的腔体消毒,维护实验室洁净环境。
强大的扩展性: 通过选配高温模块(可达85℃) 和低温模块(可至4℃),一台设备即可覆盖从常温到高温灭活,再到低温保存活化等多种应用场景,实现一机多用,投资回报率显著提升。
稳固可靠:140kg的净重体现了其扎实的用料和内部结构,有效抑制运行时的振动,保证长时间运行的平稳与低噪音。
结语
YQ-A400迷你叠加摇床,是一款在精准性、智能化与灵活性之间取得出色平衡的产品。它没有冗余浮夸的功能,每一项设计都直指实验室的核心需求。对于追求高性价比且不愿在性能上妥协的采购决策者而言,它无疑是一个经过深思熟虑的可靠选择。
立即咨询,了解更多关于YQ-A400迷你叠加摇床(振荡培养箱)的详细信息,为您的实验室增添一位得力助手。
拨打电话
留言咨询